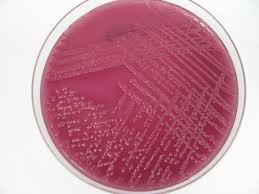
MacConkey Agar (With Salt)

Ürün Adı MacConkey Agar (With Salt)
Ürün Kodu LAB030
Marka Lab M
Ambalaj 500g
Ürün Açıklaması
Application(s): Industrial, Food, Water, Clinical
Organism(s): Enterococci & Streptococci, Staphylococci, Enterobacteriaceae / Coliforms, E.coli, Salmonella /Shigella
A selective medium for the isolation of bile tolerant organisms from faeces, urine, sewage and foodstuffs. Bile tolerant Gram-positive organisms as well as Gram-negative organisms will grow on this medium.
 Lab M
Lab M